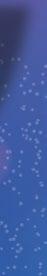

‘Bullying’ eScolar, ¿qué hay detráS?


![]()
‘Bullying’ eScolar, ¿qué hay detráS?





















































Reconocer, promocionar y fortalecer la diversidad artística del país es parte de esta celebración que impulsa la cultura y la identidad del país.
son diversas y variadas las manifestaciones artísticas en Ecuador. Y aunque su difusión, promoción y reconocimiento se hacen durante todo el año, hay un mes en el que cobran mayor realce. Se trata de agosto, conocido como el Mes de las Artes en el país, una


celebración dedicada a destacar las expresiones artísticas y culturales de esta nación.
Pero ¿cómo nació esta celebración?
En 1975, el Decreto 677, expedido en el mandato del general Guillermo Rodríguez Lara, consagró al 9 de agosto como el Día Na-


cional de la Cultura. A la par, en agosto de ese año (1975), el Gobierno creó el Premio Nacional Eugenio Espejo, un galardón que el Estado ecuatoriano mantiene hasta la actualidad y que lo otorga a personalidades e instituciones destacadas que, durante la mayor parte de su vida, han aportado a las artes, a las ciencias y a la cultura de Ecuador, se expone en la web del Ministerio de Cultura y Patrimonio. El reconocer a la cultura y el tener una dependencia que se dedique a aquello fue un proceso que comenzó incluso antes de la instauración oficial del Día Nacional de la Cultura. Fue en el gobierno de Carlos Arroyo del Río que se creó el Instituto de la Cultura Ecuatoriana, el 11 de noviembre de 1943. Un año después y en la presidencia de José María Velasco Ibarra, el 9 de agosto de 1944, se fundó la Casa de la Cultura Ecuatoriana. Esto último fue gracias al impulso interpuesto por Benjamín Carrión, un multifacético y destacado intelectual ecuatoriano que promovió la cultura y la educación en el país. Carrión, abogado, escritor, periodista, diplomático y promotor cultural, propuso y lideró la creación de una institución que promoviera la cultura y el pensamiento ecuatoriano, para fortalecer la identidad nacional y también para levantar la moral del pueblo tras los estragos que había dejado el conflicto bélico con Perú en 1941, recogen portales como el del Ministerio de Cultura y Patrimonio.
Las artes son ‘el alma’ y la identidad de una nación
“Las artes permiten tejer una red de sentidos estéticos, creativos y humanos en torno a quienes las crean, recrean, practican y representan. Son producciones simbólicas y ciertamente concretas cuya utilidad y fin es conseguir que quienes se involucren en ellas puedan ser capaces de recordarse a sí mismos que detrás de ellos existe una rica historia cultural, histórica e identitaria importante de recuperar y volver a poner en valor”, dice Wil-
s ON ví NC ulOs PER m ANENTE s ENTRE CO mu NIDADE s s mból ICA s y E sPACIOs DE sENTIDOs. N O f RACT u RAN RECONOCEN; NO bus CAN m ERCAR l A v IDA s O lO IDENTI f ICAR l A PARA PROv EER A l A s OCIEDAD y A l INDI v ID u O u NA RA zó N más PARA sENTIR sE l b RE y hum ANO ”.
Wilman Ordóñez Investigador e historiador
man Ordóñez, investigador histórico, escritor, folclorista y miembro de la Academia Nacional de Historia.
Las artes son importantes en Ecuador porque “revelan una condición espiritual del ser y hacer ecuatoriano en la diversidad, muchas veces subsumidas por falta de subsidios, fomento, preservación y memoria”, comenta y agrega que las artes importan porque no imponen. “Es libre de crearse y ejercerse y, sobre todo, educan, forman y vuelven reflexivos y críticos a quienes la practican y/o ejercen como profesión”, expone Ordóñez, quien también es licenciado en Artes Sonoras y Musicales. Durante el Mes de las Artes, en todas las provincias de Ecuador se realizan diferentes actividades para promocionar y reconocer las diversas manifestaciones artísticas. Así hay eventos que incluyen diferentes disciplinas o ramas de las artes, como música, danza, teatro, pintura, literatura, entre otras. También hay actos con exposiciones, ferias, talleres, shows y presentaciones de arte popular, por citar algunos.

Se necesitan páginas enteras para hablar de las artes y de sus más destacados exponentes en Ecuador. Cada uno tiene su aporte para la cultura del país. Son diversos los exponentes relevantes que hemos tenido en las artes en diferentes épocas o a lo largo de todo este tiempo. Hoy citaremos, solo para poner ejemplo, algunos de los nombres que han dejado huella.

Guayasamín
E SC ulT ur A
• Bernardo de Legarda
• Manuel Chili (Caspicara)
• José Olmos (Pampite)
• Yela Loffredo de Klein

l
lITEr AT ur A
• Juan Montalvo
• José de la Cuadra
• Jorge Icaza
• Alicia Yánez Cossío
• Adalberto Ortiz
• Lupe Rumazo
• Raúl Pérez Torres
• Jorge Carrera Andrade
• Efraín Jara Idrovo
PIn T ur A
• Oswaldo Guayasamín (pintor, escultor, grafista, muralista)
• Camilo Egas
• Eduardo Kingman (pintor, dibujante, grabador y muralista)
• Araceli Gilbert
• Luis Miranda
• Jaime Zapata
• Oswaldo Viteri (artista plástico: pintor, escultor, muralista y arquitecto)
• Pablo Cardoso
MúSICA
• Luis Humberto Salgado
• Mesías Maiguashca
• Julio Jaramillo
• Carlota Jaramillo
• Olga Gutiérrez


Ecuador tiene una diversidad de sitios que guardan parte de su patrimonio como museos, edificaciones coloniales, parques o sitios arqueológicos, entre otros.
rquitectura, historia, pintura, escultura, belleza patrimonial, paisajes y más son parte de la riqueza cultural del Ecuador que vive y que se pueden apreciar en diversos espacios y sitios a lo largo del país, como museos, centros culturales, mercados artesanales, complejos arqueológicos como las Ruinas de Ingapirca (en Cañar), edificaciones y espacios coloniales, entre otros.
Quito, que también es la capital del Ecuador, es una ciudad llena de historia, cultura, tradiciones y patrimonio. Su centro histórico que conserva el legado de la arquitectura colonial es uno de los puntos de referencia por visitar.
Declarado Patrimonio de la Humanidad por la Organización de las Naciones Unidas para la Educación, la Ciencia y la Cultura (Unesco), el Centro Histórico de Quito tiene más de 130 edificaciones monumentales, entre las que destacan iglesias, monasterios, museos, centros coloniales, calles, casas y edificaciones coloniales, entre otros.
Entre los espacios que destacan en el Centro Histórico de Quito están:
• Plaza de la Independencia o Plaza Grande
• La Catedral Metropolitana
• Iglesia de la Compañía de Jesús
• La Basílica del Voto Nacional
• Iglesia de San Francisco
• Calle La Ronda
Otro de los sitios llenos de cultura e historia es la Ciudad Mitad del Mundo, por donde pasa la línea ecuatorial que divide al mundo. El Museo Intiñán, tiendas, restaurantes y folclore son parte de los otros atractivos de la Mitad del mundo, en el norte de Quito.













La Perla del Pacífico cuenta también con diversos sitios patrimoniales, que reflejan su historia y cultura y que se fusionan también con la modernidad. Entre las localidades que se deberían visitar destacan:
• El centro de Guayaquil, donde hay edificaciones históricas como el Palacio municipal, la antigua sede del Club de la unión, museos como el MAAC y el Museo Nacional del Cacao, zonas como el Malecón Simón Bolívar, entre otros.
• El barrio Las Peñas
• El cerro Santa Ana es otro punto de visita. Aquí sobresalen sus coloridas casas y el Faro.
• La Catedral de Guayaquil y el parque Seminario, conocido también como parque de las Iguanas.
Cuenca tiene también una amplia gama de sitios culturales e históricos para visitar. Entre estos:
• El centro histórico de Cuenca, con edificios coloniales, iglesias, plazas y parques, donde se refleja la historia y arquitectura de la ciudad.
• Catedral de la Inmaculada Concepción, conocida por su arquitectura y cúpulas azules.
• El Parque Nacional Cajas, un área natural protegida con paisajes andinos, lagunas y ecosistemas únicos, declarado Reserva de la Biósfera por la unesco.
• Pumapungo, un sitio arqueológico que contiene vestigios de la cultura Inca.
















se conmemora el Día
Internacional del Zurdo.
La fecha invita a reconocer a personas que, desde distintos campos, han dejado huella con la mano izquierda como herramienta principal.
apesar de los avances en neurociencia, no hay una explicación definitiva sobre por qué algunas personas son zurdas. Elena Jiménez, neuropsicóloga clínica, sostiene que “la lateralidad responde a una combinación de factores genéticos y del desarrollo neurológico, principalmente en la organización del cerebro”.
El hemisferio derecho del cerebro controla el lado izquierdo del cuerpo. En personas zurdas se ha observado una activación diferente en ciertas tareas motoras y lingüísticas. Aunque se han propuesto teorías hormonales y evolutivas, no existe un único origen comprobado.
Habilidades, contexto y desafíos
Estudios realizados en el ámbito educativo y cognitivo sugieren que las personas zurdas tienden a desarrollar estrategias distintas para resolver problemas visoespaciales. Carlos Méndez, psicólogo educativo, explica que “la zurdera puede asociarse con patrones únicos de procesamiento, aunque eso no implica una ventaja universal”.
Un aspecto clave es la adaptación al entorno. Durante siglos, muchas herramientas fueron diseñadas exclusivamente para personas diestras. Aunque en la actualidad existen opciones más inclusivas, aún hay contextos donde los zurdos deben adaptarse a objetos o dinámicas que no consideran su lateralidad.

Para un niño zurdo, la escuela puede representar el primer espacio donde su lateralidad se enfrenta a rutinas establecidas. Desde la posición en el pupitre hasta el uso de útiles escolares, es importante contar con estrategias que faciliten su desarrollo.
Carlos Méndez enumera algunas recomendaciones:
• Organización del espacio: Se sugiere que el niño zurdo se ubique a la izquierda en mesas compartidas, para evitar cruces con compañeros diestros.
• Orientación del papel: Inclinando el cuaderno ligeramente hacia la derecha se mejora la visibilidad del texto.
• Materiales adecuados: Existen tijeras, reglas y cuadernos diseñados para zurdos que pueden reducir frustraciones.
• Respeto a la lateralidad: No se debe corregir ni forzar el uso de la mano derecha.
• Capacitación docente: Entender la zurdera como una diferencia, no como un problema, permite una enseñanza más equitativa.
Desde 1976, el 13 de agosto se estableció como el Día Internacional del zurdo. l a conmemoración busca generar conciencia sobre los desafíos cotidianos que enfrentan las personas zurdas, así como visibilizar su aporte en distintos ámbitos.
Más allá de lo simbólico, esta fecha permite abrir espacios de conversación sobre la inclusión, el diseño universal y la educación adaptativa.
10 % de la población mundial es zurda, según estimaciones internacionales.

1452 – l eonardo da v inci
1746 – Francisco de Goya
1881 – Pablo Picasso 1904 – Salvador Dalí 1928 – Andy Warhol

• El cerebro de los zurdos muestra una organización funcional distinta en algunas tareas.
• En el aula, pequeños ajustes en postura, ubicación y materiales pueden mejorar el desempeño de un niño zurdo.
• Artistas como Da Vinci y Picasso desarrollaron su obra usando predominantemente la mano izquierda. 1943 - Robert De Niro



Padres, docentes y alumnos tienen un papel en esta cuenta regresiva.
con el nuevo ciclo escolar en la región Sierra a la vuelta de la esquina, las familias y las comunidades educativas activan el modo regreso. Más allá de útiles escolares y uniformes, prepararse para las clases implica ajustar rutinas, establecer espacios de diálogo y fomentar hábitos que favorezcan un año organizado desde el inicio.
“Volver a madrugar es más fácil si el cuerpo ya se acostumbró”, sugiere la psicopedagoga Fanny Alulema.
Durante las vacaciones es común que los horarios cambien. Para un regreso más fluido, lo ideal es comenzar a retomar progresivamente los hábitos de sueño y alimentación una semana antes del inicio de clases. Así, el cuerpo y la mente se adaptan de forma gradual.
Tip para padres: despertar 15 a 20 minutos antes cada día ayuda a reajustar el reloj interno sin generar rechazo.
Diálogo antes que instrucciones
“Escuchar cómo se sienten ayuda más que corregirlos”, dice Alulema.
Las emociones previas al regreso son variadas. Tener conversaciones cotidianas, sin pantallas de por medio, ayuda a identificar inquietudes, temores o entusiasmo. La clave no está en resolverlo todo, sino en acompañar.
Ordenar la mochila... y la mente
“Organizar lo académico da tranquilidad emocional”, explica la experta.
Preparar útiles, revisar libros y asignar una zona de estudio en casa permite empezar con estructura. Tener todo listo reduce el estrés del primer día y envía un mensaje claro: la rutina escolar ha comenzado.
Sugerencia para el hogar: crear un rincón escolar con buena luz, libre de pantallas y con una agenda visible.
El rol de los profesores antes de las clases
“Los primeros días marcan la ruta emocional del año”, indica el capacitador Ramiro Carrión.
Los docentes también tienen preparación previa. Carrión sugiere revisar materiales, diseñar actividades de bienvenida y planear dinámicas de integración. Las primeras semanas deben enfocarse tanto en lo académico como en generar vínculos de confianza.
Escuela y familia, un solo equipo
“Estar preparados no es solo tener los libros, es tener tiempo, espacio y disposición”, destaca Carrión.
Distribuir tareas familiares, como revisar deberes, organizar horarios o planificar las meriendas, permite que todos se involucren en la rutina escolar. La participación activa genera compromiso y autonomía.
Dinámicas sugeridas para profesores
• Juegos rompehielo
• Mapa de intereses del grupo
• Contrato grupal de convivencia
• Exploración guiada del aula o biblioteca
• Rondas de presentación con preguntas abiertas

El regreso a clases no solo implica horarios y cuadernos nuevos, también es un proceso emocional que requiere acompañamiento y comprensión. La maestra Gallo comparte una mirada integral sobre cómo las familias, los docentes y las instituciones pueden contribuir a una adaptación equilibrada, donde el bienestar emocional sea parte del aprendizaje desde el primer día.
La docente recomienda que las familias acompañen a los estudiantes con empatía y paciencia, creando un entorno donde puedan expresar emociones como entusiasmo o inseguridad. “Escucharlos sin minimizar lo que sienten es clave para su seguridad emocional”, afirma.
Preparar el regreso no solo es revisar listas, sino hacerlo juntos. “Involucrar a los chicos en la organización refuerza su autonomía y sentido de responsabilidad”, sostiene.
Sentir nervios o ansiedad en los primeros días es normal. Para la maestra, es importante recordar que “cada estudiante tiene su ritmo” y que pedir ayuda es parte del proceso. “El retorno debe vivirse con
Desde lo académico, la clave está en comprender los estilos de los docentes. “Cada profesor tiene su forma de enseñar, entenderla permite que el estudiante organice mejor su tiempo y expectativas.”
“El aula debe ser un espacio emocionalmente seguro”, asegura. Recomienda incluir rutinas claras, momentos breves para hablar de emociones y actividades de integración que fortalezcan el grupo desde
Para Gallo, las instituciones deben priorizar el bienestar socioemocional. Esto implica formar a los docentes en manejo emocional, fomentar campañas de convivencia y facilitar la comunicación con las


“El éxito escolar se construye con corresponsabilidad”, afirma. La participación activa de los padres —en tareas, reuniones, conversaciones— fortalece la motivación y autoestima del estudiante.



































La ansiedad o el estrés no deben ocultarse. “Son respuestas naturales frente al cambio. Lo importante es ayudar a los chicos a identificar lo que sienten y a gestionarlo, tanto desde casa como en el aula”, señala.















































































la inseguridad o el abandono emocional son emociones no reguladas que los niños aprenden en el hogar y repiten como un grito silencioso por atención o poder.
el bullying o acoso escolar deja marcas silenciosas en la mente y en el corazón de muchos niños y adolescentes que, entre aulas y recreos, aprenden a tener miedo, a esconderse o a fingir que todo está bien.
A veces el daño no viene de un golpe o un insulto, sino del silencio de los demás, de la indiferencia o del miedo de intervenir.
La psicóloga clínica Laura Cassagne señala que detrás de un niño que agrede verbal o físicamente a otros no hay simplemente maldad, sino un llamado de auxilio. En consultas, explica, ha observado que muchos de los niños que ejercen el bullying están atravesando emociones no reguladas, como la frustración, la inseguridad o incluso el abandono emocional. “En varios casos, replican patrones que
viven en casa o buscan una forma de sentirse poderosos cuando, en realidad, se perciben a sí mismos como pequeños o invisibles”, apunta la experta.
Añade que su labor como psicóloga consiste en mirar más allá de la conducta y comprender la historia personal, el contexto familiar y las emociones no dichas. En ese contexto, el bullying escolar puede marcar profundamente la autoestima, la percepción de valía y la seguridad emocional de un niño, asegura Cassagne. “Es una forma constante de invalidación, donde el menor aprende a verse a sí mismo a través de los ojos de quien lo rechaza. Esta experiencia sostenida en el tiempo puede generar ansiedad, retraimiento, miedo al entorno social, somatizaciones e, incluso, en casos más graves, depresión”.
La especialista explica que en terapia, el tra bajo consiste en acompañar al niño a recons truir su identidad, devolviéndole la confianza en sí mismo y enseñándole a reconocer que lo que vivió no define su valor.
Prevenir el bullying es una tarea que no puede recaer solo en la escuela o el hogar. Padres y docentes tienen un rol complementario y fundamental: cuando trabajan juntos, el niño se siente más protegido, comprendido y guiado.
• Escuchar más allá de las palabras: muchos niños no dicen “me están molestando”, pero lo expresan en su conducta, su cuerpo o estado de ánimo.
• Educar en empatía y respeto desde la casa.
• Validar las emociones de todos los niños, incluso las difíciles.
• Intervenir de forma temprana y sin juzgar, buscando comprender, antes de sancionar.
• Promover espacios seguros de diálogo y confianza.
• Trabajar juntos: familia y escuela no deben actuar en paralelo, sino en alianza.

laura cassaGne psicóloGa clínica
“La autoestima no se construye con elogios vacíos, sino con presencia, validación emocional y límites claros. Cuando un niño se siente escuchado, comprendido y aceptado tal como es, va formando una base segura interna. Desde ahí es menos probable que necesite lastimar o permitir que lo lastimen. Como psicóloga recomiendo fortalecer la conexión emocional con los cuidadores, desarrollar habilidades sociales, fomentar la autorregulación emocional y enseñar a poner límites sanos desde la infancia”.

El bullying no se previene solo con reglas, sino con relaciones significativas que cuidan, enseñan y contienen asegura la experta.
El bullying puede adoptar muchas formas, pero siempre causa daño. Puede ser físico, como empujones o golpes; verbal, como burlas y amenazas; social, como excluir o difundir rumores; o digital, a través del acoso en redes.
• Extrovertidos y agresivos: pueden burlarse de ti o hacerte daño físicamente.
• Callados y escurridizos: pueden manipularte en secreto o empezar rumores hirientes de forma anónima.
• Amistosos y falsos: fingen ser tus amigos para ganarse tu confianza y luego actuar a tus espaldas.

















Detrás de cada acto hay una intención de herir o dominar. Reconocer sus señales es el primer paso para detenerlo.
• Abuso de poder: se refiere a comportamientos frecuentes, como agresión física, intimidación y amenazas, por parte de una alumna, un alumno o un grupo de estudiantes para humillar o transgredir emocionalmente.
• Repetición y sistematicidad: es la actitud que se repite constantemente con el propósito de vulnerar la condición física y emocional del alumno. Asimismo, viola los valores sociales y las conductas establecidas dentro de la escuela.


























































































Colores, texturas y herramientas, todo lo que necesitas para empezar el año escolar con pie derecho. Desde masas moldeables, bolígrafos escarchados y mochilas resistentes.


moldeable 4 oz surtido
Papel contact transparente $ 1,79
ápices de colores con punta de 4 mm 12 unidades $ 1,99



Papel contact 3 m en colores surtidos (amarilloazul- rojo-verde) $ 0,99 $ 1,79

Bolígrafo Bic punta fina blíster 4 unidades


Bolígrafo gel escarchado surtido 10 unidades Set de gomas (3 piezas) $ 1,79 $ 1,99 $ 1,99



















































































19,99








































La tecnología ha marcado la evolución en el lugar de encuentro entre alumnos y profesores. Son notables los cambios que ha experimentado el salón de clases, desde el pizarrón, las bancas, los materiales didácticos, etc. Aquí te resumimos algunos…
El profesor utilizaba tiza blanca y a veces de colores para escribir en la pizarra verde que estaba fija en una pared.
l os pequeños usaban lápices de colores para aprender a escribir mientras rayaban las paredes, al dejar volar su imaginación.


Cuando te equivocabas al escribir con un bolígrafo, tenías que recurrir a un borrador rojo con azul, que si lo frotabas mucho en la hoja, esta terminaba rota. Luego llegó el corrector líquido, un líquido blanco que había que esperar a que se secara para poder volver a escribir.
l ibros de trabajo de varias materias, con hojas para realizar actividades o carpetas para desarrollar las instrucciones del libro.


as pizarras digitales interactivas cada vez más están presentes en los centros educativos, que ya pasaron por los proyectores y las pizarras acrílicas con marcadores borrables.

os crayones borrables son una gran alternativa en la actualidad, pues los padres no deben preocuparse por volver a pintar su casa.

Bolígrafos con tinta borrable son los utilizados por los estudiantes, así no importa si se equivocan muchas veces, solo borran con la parte superior del esfero y vuelven a escribir. ¡Sin tachones ni manchones!

l as instrucciones llegan en plataformas digitales, donde un clic lleva a los estudiantes a un mundo interactivo pedagógico para que aprendan.

l os estudiantes se sentaban, entre dos o tres, en bancas de madera, donde también guardaban sus pertenencias.

l as instrucciones de las tareas escolares, las comunicaciones relacionadas con los estudiantes y las notas de las actividades se enviaban a los padres de familia en el diario o cuaderno de borrador.







Hay cómodos asientos flexibles unitarios para comodidad de los alumnos, elaborados en varios materiales y colores.

notas, citaciones y observaciones del estudiante son enviadas por plataformas a las cuales los padres acceden desde su dispositivo móvil, en cualquier momento o lugar.





































Una lonchera con alimentos naturales y balanceados, según el rango de edad escolar, mejora la concentración, el rendimiento escolar y el bienestar emocional.
en el ámbito educativo, las loncheras escolares suelen pasar desapercibidas, pero lo que niños y adolescentes consumen durante su jornada académica influye de forma directa en su rendimiento, concentración y bienestar emocional. Así lo afirma Danielle Carrera, nutricionista, esteticista y dietista, quien destaca la importancia de una alimentación equilibrada durante el día escolar.
“Una lonchera balanceada no solo aporta la energía necesaria para enfrentar las actividades diarias, sino que también mejora la atención, la capacidad de retener información y fortalece el sistema inmune, promoviendo un crecimiento adecuado”, señala la especialista. Por el contrario, cuando se incluyen productos ultraprocesados o bajos en nutrientes, es común que los niños experimenten fatiga, falta de ánimo y dificultad para concentrarse, afectando su desempeño general.

Además, es importante considerar que
las necesidades nutricionales cambian con la edad, y las loncheras deben adaptarse a cada etapa del crecimiento:
• Etapa inicial (3 a 5 años): se recomiendan raciones pequeñas, con alimentos blandos, fáciles de digerir y presentados de forma atractiva y colorida para captar su atención.
• Educación básica (6 a 11 años): a medida que crecen, las porciones deben ajustarse y ofrecer mayor variedad de nutrientes para cubrir el gasto energético propio de esta etapa tan activa.
• Educación secundaria (12 a 17 años): en la adolescencia, las loncheras deben ser más completas, con un mayor aporte de proteínas, además de alimentos que refuercen hábitos alimentarios saludables.
Según la nutricionista, una lonchera escolar saludable no quiere preparaciones complicadas, sino elecciones inteligentes y equilibradas. “Con ingredientes accesibles, es posible ofrecer opciones que nutran, motiven y acompañen el crecimiento de los niños.
Carrera recomienda que las loncheras contengan frutas frescas, proteínas, cereales integrales y frutos secos. Estos pequeños cambios marcan una gran diferencia en la nutrición diaria y, a largo plazo, en la salud y el desarrollo de los más pequeños.


• Miniemparedado de huevo cocido en triángulos + zanahorias baby + jugo natural sin azúcar.
• Tortilla de huevo con vegetales llamativos, tomate y espinaca en pedazos pequeños + rodajas de mandarina + agua.
• Porción de atún y aguacate con galletas integrales + pepino en rodajas + puñado de uvas.
• Pan de avena con mantequilla de maní natural + manzana en rodajas + agua.
• Wrap integral con pollo y vegetales + yogur sin azúcar + nueces.
• Sanduche de atún con lechuga + ensalada de frutas + agua.




• Carbohidratos de buena calidad: galletas integrales, avena, papa o arroz.
• Proteínas nutritivas: huevo cocido, atún, yogur natural, queso o legumbres.
• Frutas y vegetales frescos: manzana en rodajas, uvas, zanahorias baby, tomate cherry, entre otros.
• Grasas buenas: aguacate, semillas (como chía o linaza) y frutos secos.
• Agua natural: debe ser siempre la primera opción frente a bebidas azucaradas o jugos artificiales.


“Invertir tiempo en preparar una lonchera saludable es apostar por el bienestar del niño. No requiere complicarse, solo elegir alimentos frescos y adecuados. Comer bien también se aprende, y la lonchera es una forma de educar con el ejemplo”, apunta la nutricionista.


Peinarse ya no es solo una tarea práctica, sino una oportunidad para que los más pequeños comiencen el día sintiéndose ellos mismos.
uién no recuerda aquellas mañanas en las que mamá, entre sorbos de café y la preparación de la lonchera escolar, encontraba un momento —casi siempre al final de la rutina— para peinar a los niños antes de salir? A las niñas, con colas perfectamente apretadas, y a los niños, con peinados más sencillos y rápidos, pero no por eso menos importantes.
El ritual de peinarse antes de ir al colegio ha sido, durante años, una escena común en los hogares. Luego de arreglarse, no faltaba ese último vistazo al espejo, donde el niño aprobaba o rechazaba el resultado antes de enfrentar el día escolar.
Pero los tiempos cambian, y con ellos, la forma en que los niños se relacionan con su apariencia. Según la estilista Lady Pita, hoy los jóvenes prefieren peinados más relajados y naturales. Las niñas han dejado atrás los tradicionales moñitos blancos con pepitas para dar paso a cortes más sutiles y accesorios discretos, que reflejan su estilo sin exageraciones.
En un entorno digital cada vez más visual y conectado, la imagen personal ha adquirido un nuevo valor. La autoexpresión, incluso desde edades tempranas, se ha convertido en una forma de identidad. Ahora, más que seguir reglas, los niños buscan sentirse bien consigo mismos, proyectar seguridad y, por supuesto, verse cool
niñas
• Moños despeinados suaves con scrunchies grandes o colores neutros.
• Coletas cruzadas o bajas con estilo urbano.
• Cortes bob o midi rectos: fáciles de manejar y

niños
• Fade moderno con diseño suave o líneas
• Cabello texturizado con volumen arriba

Lavado: si el cabello de tu peque es liso y tiende a ser graso, lo ideal es lavarlo al menos dos veces por semana.
Secado y desenredado: usa una toalla de microfibra para retirar el exceso de agua. Este tipo de toalla permite un secado más rápido, evita el frizz no maltrata el cabello y no deja residuos como otras opciones. Es especialmente recomendable para cabellos ondulados y rizados.
Corte: lo más aconsejable es cortar las puntas cada dos o tres meses. Esto ayuda a que el cabello crezca más sano, mantenga su forma y suavidad, y evita la aparición de puntas abiertas o quebradizas.
Protección contra parásitos: aplica productos diseñados para proteger el cuero cabelludo de insectos indeseados. Además, revisa regularmente el cabello de tus hijos y, si es largo, procura mantenerlo recogido en una coleta firme para minimizar riesgos.

¿A qué edad debo empezar a enseñar a mi hijo a peinarse? Puedes comenzar desde los 3 o 4 años. A esa edad ya entienden instrucciones sencillas y están desarrollando habilidades motrices finas.
¿Qué tipo de productos debo usar para el cabello de mi hijo? Opta por productos formulados especialmente para niños, como champús suaves y acondicionadores sin sulfatos ni químicos agresivos.
¿Cómo puedo hacer que el momento del peinado sea divertido? Involucra a tu hijo en el proceso: déjalo elegir su peine o cepillo con diseños divertidos, pon música alegre o cuéntale cuentos mientras lo peinas. Así será una rutina que ambos disfrutarán.
¿Sabías qué..?
Durante la adolescencia, el cuerpo experimenta múltiples cambios que también afectan el cuero cabelludo y el cabello. Entre los más comunes se encuentran:
1. Aumento de la grasa capilar
2. Aparición de caspa o dermatitis seborreica
3. Caída temporal del cabello
4. Cambios en la textura
5. Primeras canas
Los productos diseñados para tu tipo de cabello son los mejores para ti.
Proteger el cabello del calor es esencial.
El acondicionador hace que el cabello se vuelva graso.
El cabello puede dañarse con la exposición al sol.

El cabello graso y con caspa tiende a caerse más.
El estrés no afecta el cabello.
Su preparación es rápida y lleva ingredientes como verde, maní, limón, ajo y cebolla, que realzan su sabor.

la cocina manabita está llena de delicias que conquistan el paladar de quienes se adentran en su riqueza culinaria. En esta ocasión, el chef Felipe Campana compartió una receta original y exquisita: colonche de camarón, durante una masterclass del programa Mejora tu vida, transmitido por el canal de YouTube Tía TV
Esta sabrosa preparación combina patacones troceados, pasta de maní y camarones, creando un plato completo que, a diferencia de muchas recetas ecuatorianas, no necesita arroz como acompañamiento. Sin embargo, como buen ecuatoriano, siempre es válido complementarlo con un arrocito, si así se prefiere.

Tiempo de preparación: 40 minutos
Dificultad: fácil
Ingredientes
2 verdes
2 tazas de aceite para freír
1
½ tazas de camarones limpios
3 cucharadas de aceite de achiote
½ cebolla colorada en cubos pequeños
½ pimiento verde en cubos pequeños
½ rama de cebolla blanca picada finamente
1 diente de ajo rallado
1 cucharadita de orégano
½ cucharadita de comino
1/3 de taza de pasta de maní
2 tazas de fondo de pescado jugo de un limón
2 cucharadas de cilantro picado sal al gusto
Preparación



1. Pela y corta los verdes en rodajas gruesas. Fríelas en aceite caliente hasta que estén doradas. Luego aplástalas para formar los patacones y resérvalos.
2. En una sartén con un poco de achiote sofríe la cebolla colorada, la cebolla blanca y el pimiento verde picados. Cocina hasta que estén suaves. Agrega sal, comino y orégano al gusto.
3. Baja el fuego y agrega el ajo picado al refrito. Cocina suavemente para que no se queme y suelte su sabor.
4. En un bol mezcla los camarones limpios con sal, comino y jugo de limón. Deja reposar durante unos 25 minutos para que absorban los sabores.
5. Una vez que el refrito esté listo, incorpora la pasta de maní y mezcla bien hasta que se disuelva.
6. Agrega un poco de fondo de camarón (o de pescado si prefieres). Revuelve para integrar bien los sabores.
7. Añade los camarones al refrito con el fuego bajo. Cocina hasta que hierva suavemente. Justo antes de retirar del fuego, añade un poco de cilantro fresco picado.
8. Trocea los patacones en pedazos medianos y agrégalos a la preparación. Revuelve todo con cuidado para que se impregnen del sabor del refrito y del maní.
9. Prueba la preparación y corrige la sal si es necesario.
10. Sirve caliente, decora con más cilantro fresco por encima ¡y disfruta de este delicioso plato tradicional de Manabí!
para pelar bien el verde:
• Golpéalo suavemente antes de pelarlo.
• Pásalo por el chorro de agua para facilitar el proceso.



• La salsa inglesa es un excelente potenciador del sabor del camarón.
• Remojar los patacones en agua con vinagre antes de freírlos les da un toque más crujiente.
• Para preparar un buen fondo de pescado, hierve el espinazo con vegetales durante no más de 35 minutos, ya que pasado ese tiempo puede liberar amoniaco.
Conoce
la historia, características y amenazas del león, el único felino que vive en manada y símbolo de la vida salvaje africana.
los leones son los únicos felinos que viven en grupos sociales estables conocidos como manadas. Estas unidades familiares pueden estar conformadas por hasta tres machos, una docena de hembras y sus crías. Todas las leonas de una misma manada están emparentadas y, por lo general, las hembras jóvenes permanecen en el grupo al llegar a la adultez. En cambio, los machos jóvenes suelen abandonarlo o ser expulsados, lo que los obliga a formar nuevas manadas. Como todos los felinos, los leones son cuadrúpedos y mamíferos. Poseen una larga cola, un pelaje corto de tonalidad amarillenta, y en el caso de los machos, una distintiva melena que puede variar entre rubia y oscura. Su dieta es exclusivamente carnívora. Son cazadores expertos, capaces de inmovilizar a sus presas con sus garras y desgarrar grandes porciones de carne con sus potentes colmillos.
l a musculatura del león está altamente desarrollada, especialmente en sus extremidades posteriores, lo que le permite alcanzar gran velocidad al correr. Sus músculos son elásticos, con un tono muscular característico, y son contráctiles, es decir, pueden acortarse en respuesta a estímulos, generando movimiento en las estructuras a las que están unidos.

El cráneo del león está conformado por varios huesos, al igual que el del ser humano. Entre ellos se encuentran el frontal, parietal, temporal, occipital, esfenoides y etmoides.
Hábitat
El león es una especie adaptada a la sabana africana, un entorno de planicies abiertas donde puede alcanzar altas velocidades durante la caza. Suelen refugiarse del calor bajo la sombra de acacias y otros árboles característicos del este y sur del continente. Entre sus presas se encuentran antílopes, emús y otras especies endémicas.
Actualmente, la mayoría de los ejemplares vive en regiones protegidas del este y sur de África, con una población estimada en menos de mil leones adultos.

Su tamaño
os leones son animales de gran tamaño y cuerpo robusto. l os machos pueden pesar entre 160 y 260 kilogramos, mientras que las hembras oscilan entre los 120 y 182 kilogramos. En longitud, llegan a medir cerca de tres metros, contando desde la cabeza hasta la punta de la cola.
Clasificación científica
• Nombre científico: panthera leo
• Familia: félidos
• Orden: carnívoros
• Reproducción: entre 2 y 4 crías por camada, luego de una gestación de 105 a 115 días.


Los leones dedican alrededor de 20 horas al descanso y la inactividad. Sus momentos de socialización se dan principalmente al atardecer, mientras que sus actividades de caza suelen ocurrir de noche. Caminan aproximadamente dos horas al día y destinan unos 50 minutos diarios a la alimentación.
• Actualmente existen dos subespecies de leones: el africano y el asiático.
• Los leones africanos habitan las sabanas y praderas desde hace más de 124.000 años.
• Solo los machos desarrollan melena, que puede alcanzar hasta 20 centímetros de largo.
• Alcanzan la madurez reproductiva entre los cuatro y cinco años.
• Las hembras son las principales cazadoras del grupo. La melena del macho, aunque vistosa, dificulta el camuflaje.
• Su rugido puede escucharse a una distancia de hasta ocho kilómetros.
• Las hembras recién paridas suelen mantenerse apartadas de la manada por cerca de un mes.

• El lobo y el león

• Mia y el león blanco
• Pérdida de hábitat: históricamente ocuparon los leones se han reducido drásticamente debido al avance de las actividades humanas y el cambio climático. Actualmente, ocupan solo el 8 % de su antigua área de distribución. Muchas poblaciones están aisladas en zonas protegidas.
• Conflictos con humanos: cuando los leones invaden territorios agrícolas o ganaderos, representan un riesgo para las comunidades locales, ya que pueden atacar al ganado e incluso a personas. Como respuesta, muchos leones son eliminados en actos de represalia.
• Caza furtiva y comercio ilegal: la caza de presas silvestres para consumo humano reduce las fuentes de alimento del león. A medida que disminuye la población de presas, también lo hace la cantidad de leones en libertad.
Estas son algunas películas que te recomendamos ver:



del león macho no solo le da un aire majestuoso, sino que cumple una función protectora: resguarda zonas vitales como el cuello y la cabeza durante enfrentamientos.

Cada 10 de agosto se celebra el Día Mundial del León, una fecha que busca generar conciencia sobre la importancia de conservar a esta especie emblemática, cuya supervivencia se encuentra en riesgo.


• león, la bruja y el armario

• La bestia



• El rey león (live action y caricatura)

• Nacida libre





• Mufasa: el rey león • Pride
• Madagascar

• Salvaje








Almacenes Tía muestra que hay detrás de las marcas que se encuentran en sus perchas, liderando la iniciativa crecimiento compartido enfocada en su cadena de valor.
crecimiento Compartido forma parte del pilar Propuesta de Valor dentro de la Estrategia de Sostenibilidad de Almacenes Tía, llamada El Efecto Tía, que busca generar un impacto positivo integral para fortalecer a su cadena de valor.
La iniciativa nace en 2018 con ruedas de negocios para las pymes y con el paso de los años su enfoque ha ido cambiando, según las necesidades de los negocios proveedores de Almacenes Tía.
Es así que se ha desplegado, como parte de Crecimiento Compartido, la Escuela de Proveedores, un programa que evidencia el claro compromiso de Almacenes Tía con el desarrollo y fortalecimiento de los conocimientos de las pequeñas y medianas empresas (pymes). Este programa brindó más de 50 horas de capacitación en 2025 a alrededor de 40 pymes en áreas como marketing, desarrollo de negocio, sostenibilidad, logística, calidad y herramientas financieras. De esta manera, la cadena de supermercados contribuye al desarrollo y competitividad en el mercado. De la misma manera, las pymes tienen la

E s TA CO l A b ORACI ó N CON Tí A vA más A llá DE u NA sI m P l E REl ACI ó N CO m ERCIA l. lA Es C u El A DE P ROv EEDORE s y C RECI m IENTO CO m PARTIDO s ON u NA C l ARA DEm Os TRACI ó N DEl CO m PRO m s O DE Tí A CON El DE s ARRO llO DE sus s OCIOs E s TRAT é GICOs, m P uls ANDO u N CRECI m IENTO mu T u O y f ORTA l ECIENDO
El TE j IDO Em PRE s ARIA l EC uATORIANO Es TA m Os AGRADECIDOs POR E s TA OPORT u NIDAD Q u E NOs h A PER m ITIDO CRECER DE m ANERA sól IDA y CON f IA m Os EN sEG u IR CON s TR uy ENDO ju NTOs u N fu T u RO PR ósPERO ”.
Jefferson Sánchez Gerente General de vecipan
oportunidad de formar parte de un podcast de Almacenes Tía que lleva el mismo nombre de la iniciativa enfocada en este segmento: Crecimiento Compartido.
Con este podcast, transmitido por el canal de YouTube Tía Tv, se dan a conocer historias de éxito de diversas empresas y emprendedo res ecuatorianos, destacando su innovación, liderazgo y dedicación. En cada episodio, se entrevista a directivos de diferentes marcas para conocer los detalles de sus productos y su trayectoria.
A través del programa Crecimiento Com partido, se han dado a conocer las historias de 12 pymes en diversas plataformas digitales.












































